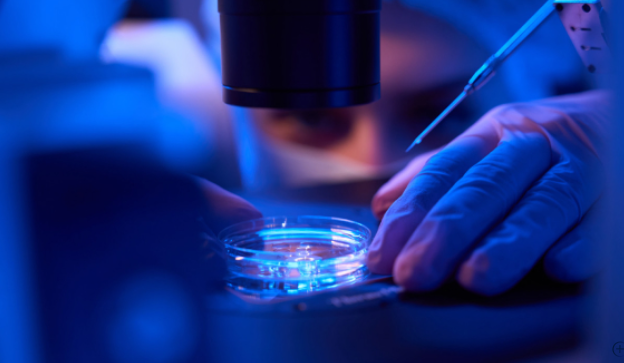

Immunogenicity can reshape a biologic’s exposure, efficacy, and safety profile, so anti-drug antibody (ADA) screening must be both sensitive and specific before it reaches the clinic. Regulators (FDA/EMA/NMPA) expect a fit-for-purpose validation that proves the assay works across real patient matrices and under routine conditions. The roadmap below distills best practices, from cut-point statistics to drug-tolerance engineering, so your screening assay can confidently feed confirmatory and neutralizing workflows and support data-driven DMPK and clinical decisions.
ALSO READ: How to Optimize Intrathecal Injection Protocols?
Step-by-step Validation of ADA Screening Assays
The most reliable programs move from foundational design to statistical qualification, then stress-test ruggedness. Here’s how to build that sequence.
Choose a format and set the MRD.
Select a platform (bridging ECL/ELISA are workhorses) and define the minimum required dilution (MRD) that balances matrix effects with sensitivity. Optimize incubation times, temperatures, and buffers to minimize non-specific binding while preserving low-level signal near the decision boundary.
Define controls and reference materials.
Pick a positive control (PC) antibody (often polyclonal, isotype-matched) and characterize its affinity and stability. Establish negative controls and two QC levels—low QC near the cut-point and high QC for dynamic range. These materials anchor sensitivity, precision, and long-term trending.
Establish the screening cut-point statistically.
Collect treatment-naïve individual matrices (typically ≥50 donors per species). After outlier handling and normalization, compute a nonparametric percentile (commonly 95th–99th) to set the screening cut-point. Lock the algorithm (transformations, plate factors) so the decision rule is reproducible across runs and sites.
Prove confirmatory specificity and set inhibition criteria.
Run a competitive inhibition step using excess unlabeled drug to quench the true ADA signal. Determine a confirmatory cut-point and specify the minimum % inhibition (e.g., ≥30–50%) that reclassifies a screen-positive as confirmed positive. Document tolerance to closely related proteins to limit cross-reactivity.
Quantify sensitivity near the decision boundary.
Prepare serial dilutions of the PC in the matrix and identify the lowest concentration consistently called positive after the confirmatory step. Report the method sensitivity (e.g., ng/mL) with confidence intervals, using multiple days, analysts, and reagent lots to reflect routine variability.
Build drug tolerance with targeted pretreatments.
Excess circulating drug can mask ADAs. Validate acid dissociation, ACE, SPEAD/BEAD, or PandA to liberate immune complexes and establish drug-tolerance curves (PC fixed, drug titrated). Choose the approach that meets clinical needs without inflating background—critical for high-dose, long half-life biologics and ADCs.
Demonstrate selectivity and interference resistance.
Test diverse individual matrices (lipemic, hemolyzed, icteric), common co-medications, rheumatoid factor/heterophile antibodies, and soluble target interference (use target-blocking antibodies if needed). Confirm that true positives remain positive and true negatives stay negative under these conditions.
Precision, robustness, and stability.
Assess intra-/inter-assay precision (%CV on QCs), ruggedness (analysts, instruments, days, lots), and robustness (small, intentional deviations in time/temperature). Establish stability for samples and reagents (bench-top, freeze–thaw, long-term, reinjection). Monitor hook effect and high-dose prozone to avoid false negatives at very high ADA levels.
System suitability and QC rules for routine use.
Define plate maps, acceptance criteria (blank/NC behavior, QC recoveries), control charts, and actions for out-of-spec runs. Align documentation to FDA/EMA guidance; for immune-cell-targeting drugs, address NMPA expectations (e.g., cytokine release considerations) in the overall risk plan.
Connect results to DMPK and escalation testing.
Pre-specify how screen/confirm outcomes trigger NAb assays and how ADA status is interpreted alongside PK exposure (e.g., unexpected clearance spikes). For ADCs, orthogonal ICP-MS/MS can quantify elemental payloads to corroborate linker stability when ADA signals emerge.
Conclusion
Validating an ADA screening assay is a disciplined progression: choose the right format, set a robust MRD, anchor the immunogenicity testing methods with well-characterized controls, and lock in statistics for screening and confirmatory cut-points. Then prove sensitivity, drug tolerance, selectivity, precision, robustness, and stability under real-world constraints. With clear QC rules and a plan to integrate PK/NAb data, your assay becomes a reliable gatekeeper—flagging true immunogenicity risks early and supporting confident clinical decision-making.
YOU MAY ALSO LIKE: How Does DMPK Impact the Success of Clinical Trials?
